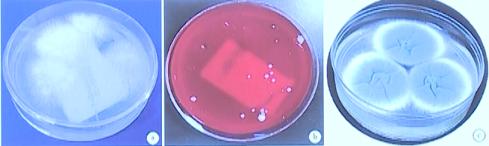

基因组测序目前在下呼吸道感染性疾病的诊断中应用越来越广泛,特别是对病原的检测。但是随着宏基因组测序(mNGS)技术的广泛应用,临床发现mNGS在针对真菌、分枝杆菌的测序工作中,其对“破壁技术”的要求较高,技术难度也较大。此外,如何解读mNGS报告,如何“猜测”出有效序列,下一步应该如何去验证“猜测”,如何从大量的病原体中提取到目的核酸序列,保证检测结果的准确性,似乎也成为了一个难题。因此,靶向测序(tNGS)技术应运而生。由于靶向测序(tNGS)灵敏度高、准确度高、检测成本低且相对快速,其在结核及结核耐药检测、脑脊液病原体鉴定、早产儿下呼吸道感染的诊断等领域都有极高的价值。那么,宏基因组测序(mNGS)与靶向测序(tNGS)在下呼吸道感染性疾病诊断过程中应当如何选择,这两种技术的优势和各自的局限性是什么,中日医院国家呼吸医学中心鲁炳怀教授在本次讲座中就为大家进行了详细的解读。

一、mNGS技术的选择与局限性
我们以下呼吸道感染为例,其病原类别非常多,包括病毒、细菌、非典型病原体、真菌、分枝杆菌等。不同人群、不同季节、不同年龄阶段,诱发疾病的病原是不一样的。而用常规的微生物培养检测方法,只能培养出一部分病原菌。也正是因为常规微生物检验的“不给力”,很多临床医生会选择绕过临床微生物室,选择宏基因组测序(mNGS)。
目前看来, mNGS是一个非常特殊的技术,它可以对所有的病原进行检测。相对而言,通过mNGS对病毒进行测序较为简单,技术上难度相对较小。但是针对真菌、分枝杆菌的测序工作,其对“破壁技术”的要求较高,技术难度也较大。
目前,免疫抑制人群数量的增加、侵袭性真菌病(IFD)患者人数也不断增加,给患者造成了严重的经济负担。而随着引起下呼吸道感染的侵袭性念珠菌、曲霉菌、毛霉菌、新型隐球菌、卡氏肺孢子菌、地方流行性真菌、罕见真菌等的检出率越来越高,让临床医生头疼的问题是很多患者做了mNGS后却发现了三个甚至多个真菌、分枝杆菌的扩增片段,难以明确诊断。而如何解读mNGS报告、如何“猜测”出有效序列、下一步应该如何去验证“猜测”、如何结合患者的影像学结果和临床症状调整用药从而提高病原覆盖率,似乎成为了临床MDT或者会诊的主旋律。如何从大量的病原体中提取到目的核酸序列,从何保证检测结果的准确性,成为了一个难题。
在临床诊断感染的时候,如果病原载量高,无论是传统的微生物技术,还是宏基因组测序(mNGS)、靶向测序(tNGS)都是没有什么问题的。现在的难题是当病原载量较低时,mNGS检测报告应该怎么去分析和解读。
mNGS另一个主要的问题是为了提高灵敏度,降低了特异度。不同的公司之间结果可比性比较差,除非是病原载量比较多的时候才有一定的可比性。当病原量少的时候,不同的公司得到的结果是千差万别的。为了能够检出的病原量更多,一些特异性数据库中也纳入了非特异的片段,这样导致了和数据库比对以后的结果,未必是特异的,更无法明确诊断。因此建议,应在普通库的基础上再建一个二级库来标定扩增序列是否特异、结果是否可靠。以分枝杆菌属的测序为例,分枝杆菌属是一类细长略带弯曲,有时呈分枝状的杆菌,细胞壁还要大量脂质。现在很多患者感染新冠、流感后易混合细菌感染或继发鸟分枝杆菌、脓肿分枝杆菌的感染,需要鉴别诊断。而这类患者的mNGS结果常出现鸟分枝杆菌、脓肿分枝杆菌有2~3个序列的情况,难以判断患者是否合并继发感染了分枝杆菌。
二、“传统显微镜涂片镜检与培养” VS 宏基因组测序(mNGS)
(一)显微镜涂片镜检:通过直观的观察,可见人体炎症反应的状况,如白细胞聚集、吞噬情况,可以帮助临床明确病原的存在,但是灵敏度不高。
(二)培养是感染诊断的金标准,但时间周期长。培养出活的致病菌落是药敏试验的前提:
1.隐球菌属与曲霉菌相对毛霉菌容易培养;
2.分枝杆菌推荐采用液体培养的手段,可提高阳性率,缩短报告时间。
在所有感染性疾病中,超过30%的呼吸道感染、超过40%~50%血流感染、以及超过50%~60%脑炎和脑膜炎,通过传统的病原学检测手段(直接检查、抗原检测、PCR、分离与培养)无法鉴别其病原体。
微生物培养可以分离的常见病原体

(三)宏基因组测序(mNGS)的靶标是核酸,可报告耐药基因
1.碳青霉烯酶耐药基因(对于肠杆菌目细菌);
2.mecA基因(对于葡萄球菌);
3.结核分枝杆菌的耐药基因等。
从传统微生物检验的角度来解读mNGS的结果发现,mNGS被“扩大化”了,我们需要一种方法去校准mNGS的结果,判断其是否可靠。而如果医院的基础微生物检测能力比较弱,就很难解决这个问题。在 mNGS 应用的背景下,传统微生物检测应该如何发展、如何去建设,如何去增强是重点,而不是削弱。很多欧美国家mNGS并没有完全铺开,但是他们的诊疗工作却开展的很好。从这个角度分析,基础的微生物检测能力是非常重要的。
mNGS加深了人们对鹦鹉热衣原体、人疱疹病毒(1~8型)、钩端螺旋体、少见NTM与隐球菌等病原体的认识。但是数据库比对的结果是否可靠、是否是病原体,如果是病原体是否需要治疗,是否达到感染的标准,还需要更深入的探讨。往往更需要和传统方法(常规微生物镜检与培养、组织病理染色、影像学等)相结合。
三、靶向测序(tNGS)
靶向测序(tNGS)基于超多重PCR技术,可进行靶向病原检测,突破病原检测的局限性。
(一)特异性增加目标病原体核酸序列数和比例,提高目标微生物的支持reads数和覆盖度,保证难检/苛养/低载量病原的检出。
(二)毒力基因的检测:为区分致病菌和定植菌提高基础。
(三)耐药基因的检测:与致病病原、耐药表型相合。
由于靶向测序(tNGS)灵敏度高、准确度高、检测成本低且相对快速,其在结核及结核耐药检测、脑脊液病原体鉴定、早产儿下呼吸道感染的诊断等领域都有极高的价值。靶向测序(tNGS)代表了很重要的一个发展方向,特别是对无需检测过多病原体的患者。
四、宏基因组测序(mNGS)与靶向测序(tNGS)的选择
(一)mNGS在发热待查、不明原因感染或发热、排除感染以及对罕见、疑难、反复、慢性感染的诊断有很大的帮助
(二)tNGS可以针对基层群体/常见感染患者的常规检测手段,包括但不限于各种系统社区获得性感染、医院获得性感染等。超多重PCR(正向富集)+高通量测序(NGS)的靶向测序(tNGS)技术可以满足98%临床应用场景,可以实现DNA和RNA共检,无需分开送检。具有快(实验TAT最快12h)、敏(敏感度优于mNGS)、廉(高性价比)、定(病原精确定量)的特点。
(三)下呼吸道感染需要综合诊断
下呼吸道感染需结合实验室病原学检测、影像学、临床症状、病理学以及生物标记物和急性相炎症反应指标等综合诊断。而mNGS/tNGS/多重分子检测的未来我们认为:
1.<10个靶标、小panel,可使用荧光PCR技术(Gene Xpert);
2.10-50 个靶标、中小panel,可使用微流控POCT(Filmarry);
3.200-1000个靶标、中panel,可使用panel tNGS;
4.无预定靶标、大panel,可使用mNGS。
小 结
任何一个技术都不能单独解决所有问题,mNGS/tNGS技术也没有摆脱核酸检测的局限性,检测结果的及时需要结合传统微生物学诊断技术及临床综合分析和判读。




